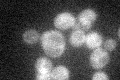
YNL119W
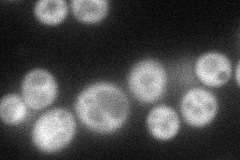
YNL119W
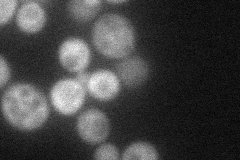
YNL119W
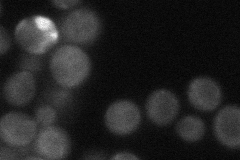
YNL119W
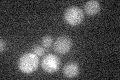
YNL119W

View description
Protein required for thiolation of the uridine at the wobble position of Lys(UUU) and Glu(UUC) tRNAs; has a role in urmylation and in invasive and pseudohyphal growth; inhibits replication of Brome mosaic virus in S. cerevisiae
Localization:
Intensity:
Fold change:
Significance:
-
C’ GFP library in SD
cytosol29.55 -
N' NOP1pr-GFP in SD
cytosol50.4913 -
N' TEF2pr-mCherry in SD
cytosol36.4611 -
N' NATIVEpr-GFP in SD
cytosol31.4147 -
N' TEF2pr-VC and Cyto-VN in SD

cytosol27.1163 -
C’ GFP library in SD+DTT

cytosol25.050.84No -
C’ GFP library in SD+H2O2

cytosol29.040.98No -
C’ GFP library in Starvation Media
cytosol16.350.55No -
C’ GFP library on the background of Pup2-DaMP

N/A -
C’ GFP library on the background of CCT mutant

N/A0N/AYes
